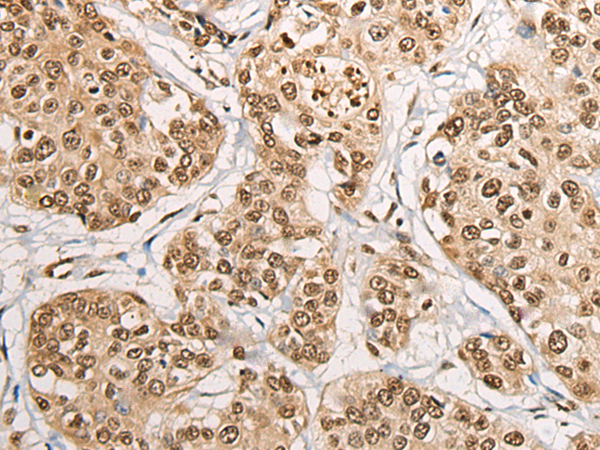
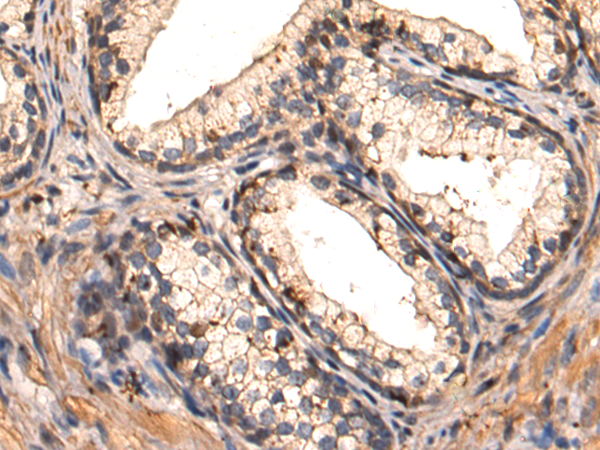
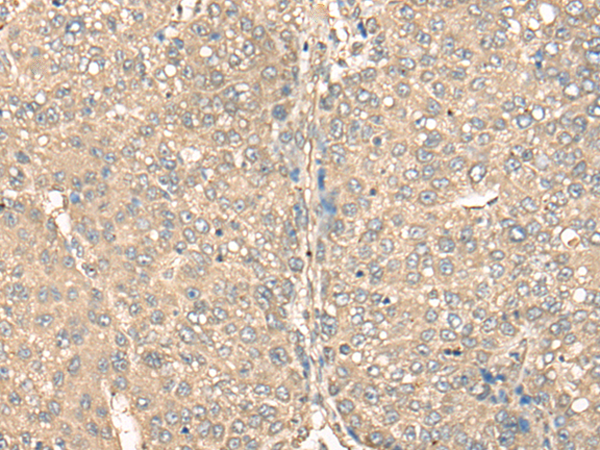
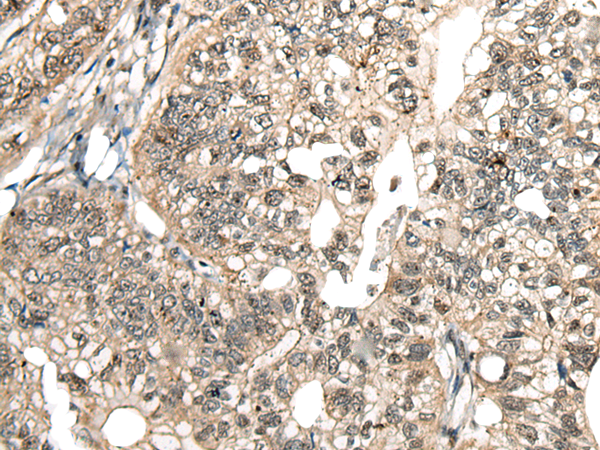
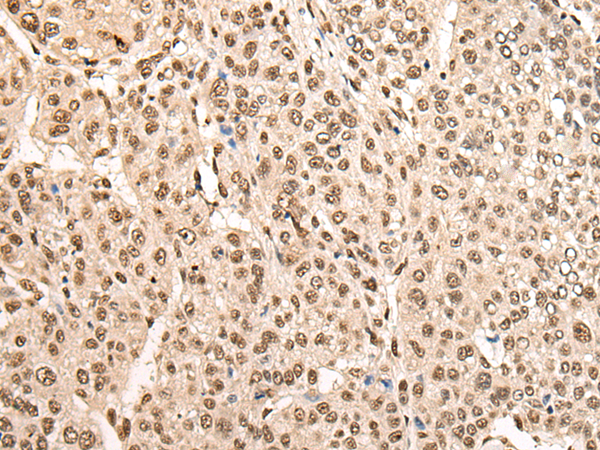

-
分类: 科研抗体货号: P09376别名: BTBD15; ZNF851; HSPC063应用: IHC反应种属: Human
-
分类: 科研抗体货号: P09360别名: BHC80; BM-006应用: WB,IHC反应种属: Human, Mouse
-
分类: 科研抗体货号: P09375别名: CAPH; BRRN1; CAP-H; MCPH23应用: WB,IHC反应种属: Human, Mouse
-
分类: 科研抗体货号: P09359别名: BEX2; HBEX2; HGR74-h应用: IHC反应种属: Human
-
分类: 科研抗体货号: P09374别名:应用: IHC反应种属: Human
-
分类: 科研抗体货号: P09358别名: CRYG8; CTRCT20应用: WB反应种属: Human, Mouse, Rat
-
分类: 科研抗体货号: P09373别名: MCT; BRIT1应用: IHC反应种属: Human
-
分类: 科研抗体货号: P09357别名: DHRS6; EFA6R; SDR15C1; UCPA-OR; UNQ6308; PRO20933应用: WB,IHC反应种属: Human, Mouse, Rat
-
分类: 科研抗体货号: P09372别名: BRF; CFDS; hBRF; BRF-1; GTF3B; TAF3C; TAF3B2; TF3B90; TAFIII90; TFIIIB90; HEL-S-76p应用: IHC反应种属: Human
-
分类: 科研抗体货号: P09356别名: BCDO2; B-DIOX-II应用: IHC反应种属: Human, Mouse

鄂公网安备42018502007531号
鄂公网安备42018502007531号

